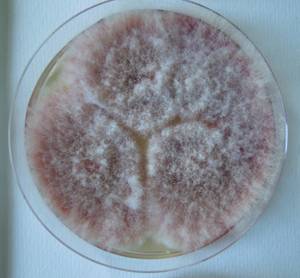
MSU_FS-02540 01, Район Кон Плонг (Kon Plông district), Kon Tum province (Vietnam)
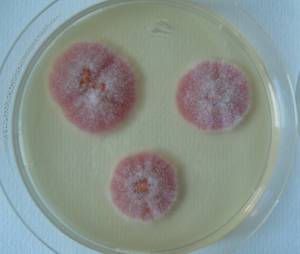
MSU_FS-02539 01, Район Кон Плонг (Kon Plông district), Kon Tum province (Vietnam)
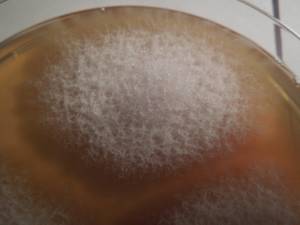
MSU_FS-01476, Район Тан Фу (Tân Phú districts), Đồng Nai province (Vietnam)

Total items: 6
Total pages: 1
Organisms
- Specimen ID
- 0000000905540
- Species
- Fusarium proliferatum
- Strain
- MSU_FS-02540
- Place of isolation
- Район Кон Плонг (Kon Plông district), Kon Tum province (Vietnam)
- Placename
- Манг Кань (Măng Cành commune)
- Specimen ID
- 0000000905538
- Species
- Fusarium proliferatum
- Strain
- MSU_FS-02539
- Place of isolation
- Район Кон Плонг (Kon Plông district), Kon Tum province (Vietnam)
- Placename
- Манг Кань (Măng Cành commune)

- Specimen ID
- 0000000905220
- Species
- Fusarium proliferatum
- Strain
- MSU_FS-02208
- Place of isolation
- Район Лак (Lắk district), Đắk Lắk province (Vietnam)
- Placename
- Бонг Кранг (Bông Krang)

- Specimen ID
- 0000000905218
- Species
- Fusarium proliferatum
- Strain
- MSU_FS-02207
- Place of isolation
- Район Тан Шон (Thanh Sơn district), Bến Tre Province (Vietnam)
- Placename
- Суан Шон (Xuân Sơn commune)

- Specimen ID
- 0000000904540
- Species
- Fusarium proliferatum
- Strain
- MSU_FS-01620
- Place of isolation
- Район Винь Куу (Vĩnh Cửu districts), Đồng Nai province (Vietnam)
- Placename
- Ма Да (Mã Đà)
- Specimen ID
- 0000000904314
- Species
- Fusarium proliferatum
- Strain
- MSU_FS-01476
- Place of isolation
- Район Тан Фу (Tân Phú districts), Đồng Nai province (Vietnam)
- Placename
- Нам Кат Тьен (Nam Cát Tiên)